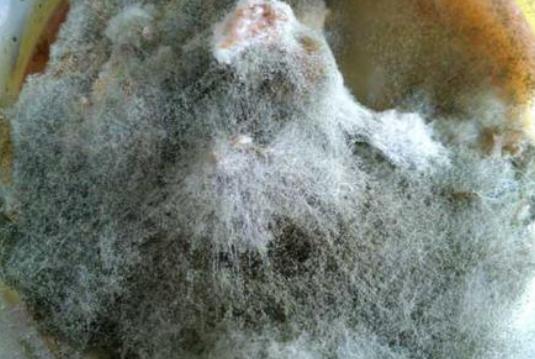
霉菌毒素对鸡群的危害,鸡霉菌引起呼吸道感染怎么办

家禽的健康,牵连着众多养殖户,它关联着我们的收益、欢乐。为了提高众多养殖户的收益获得更多的开心、欢乐。下面跟着白老师一起学习养鸡技术。
鸡群主要是由于食入黄曲霉毒素、玉米赤霉烯酮、赫曲霉毒素、呕吐霉素以及T-2毒素等出现发病。霉菌毒素可来自饲料,主要包括玉米、豆粕、鱼粉等。例如,在玉米收获季节频繁下雨,使其在采收前就出现发霉或者收获后没有及时晾干而出现发霉变质,此时就含有大量霉菌而产生霉菌毒素。一般来说,霉变玉米中主要含有黄曲霉毒素、呕吐霉素、赤霉烯酮等;豆粕和鱼粉在存储过程中也能够感染霉菌,从而含有霉菌毒素。另外,霉菌毒素可来自垫料,如地面养鸡主要以木屑、麦秸、稻壳、花生壳等作为垫料,当环境温度过高、湿度过大就容易发霉,鸡日常饲养中经常采食掉于垫料上的饲料或者直接采食垫料,从而容易感染霉菌或者摄入霉菌毒素。此外,霉菌毒素还可来自雏鸡,也可经由种鸡转移到体内。当种鸡食入霉变饲料,就会在卵黄中不断蓄积霉菌毒素,则在种蛋孵化后期以及出壳后导致霉菌毒素在吸收卵黄的同时进入雏鸡体内。

黄曲霉毒素主要会导致中毒性肝炎,玉米赤霉烯酮主要造成繁殖机能降低、胎儿畸形,赭曲霉毒素主要会导致肾病和肝细胞坏死,呕吐毒素主要是导致肾病和免疫功能失调,T-2毒素主要导致繁殖机能异常、流产、死胎。每种霉菌毒素可能具有多个靶器官,或者可作用于多种类型的细胞。当机体同时感染多种霉菌毒素,其所造成的危害程度并非简单的相加,而常常会成倍增加。
目前对禽类危害最大的霉菌有以下几种:
(1)烟曲霉菌毒素主要侵害呼吸系统表现肺和气囊以及肠系膜上有结节为特征性病变。
(2)玉米赤烯酮 雌激素可引起产蛋下降 受精率不高 以及假公鸡
(3)T-2毒素 可引起免疫抑制 脂溶性 可引起白色念珠菌 以及肌胃炎和骨骼发育不良以及卵巢萎缩
(4)黄曲霉菌毒素与黄曲霉协同侵害肾
(5)呕吐毒素 镰刀菌及青霉菌等。
而霉菌与霉菌之间也存在着叠加效应。
鸡霉菌中毒的症状图片蛋鸡霉菌毒素中毒图片鸡感染霉菌毒素症图片治疗鸡霉菌的特效药鸡霉菌感染的症状图片鸡霉菌感染解剖图片鸡霉菌中毒用什么药好鸡霉菌中毒几天能好

二【流行特点】
主要侵害鸡鸭鹅等禽类,各年龄均可感染,幼禽感染率与死亡率最高,成禽主要是慢性接触性死亡,容易引起机体免疫力下降激发感染其他并发症引起死亡,发霉的垫料和玉米漏子为传播媒介,主要通过呼吸道感染,原料发霉和卫生条件差为主要诱导原因。
【临床表现】
机体消瘦 呼吸次数增加,甩头 时而张口伸颈呼吸有摩擦音,眼睛鼻子有粘液流出
喝水量增加 料减少 精神不佳 出现下痢 以及神经症状,中后期本病容易与浆膜炎和副粘;
【解剖症状】肺部有黄色颗粒样病变括气囊以及肠系膜上都可见针头大小到黄色颗粒样结
节,耐过得可见成熟的孢子破裂里面有霉菌菌丝。肝脏呈自脂溶性肝炎上面有坏死灶。孵化过程中可见蛋的气室有霉菌斑。
解决方案:天下无霉
能饮水的霉菌药,不单单是预防用的。曲鸡体内霉菌,饲料霉菌。
是治疗型的霉菌药,提高消化道吸收能力提高肠道活动能力深度治疗霉菌,快速停止死亡。
你学会了吗?喜欢就关注我 学习更多养殖技术!私信我免费领取(鸡鸭鹅)养殖技术,预防程序,预防程序。帮忙转发 谢谢!